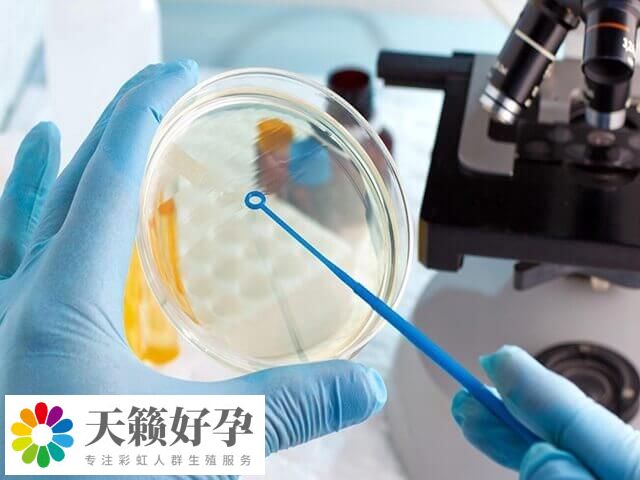
0Bb4QSGm6r1737108166223.jpg

試管移植后發(fā)冷是不是失敗了
試管移植后部分患者可能會有一些癥狀感覺,比如有的可能出現(xiàn)身體發(fā)冷,這并不一定意味著移植失敗,畢竟體溫變化與移植成功沒有直接聯(lián)系,如果患者身體發(fā)冷,且伴隨流鼻涕或是打噴嚏,那么可能與感冒著涼有關(guān)。不過因個體差異較大,患者出現(xiàn)這類情況,也可能是胚胎移植成功引起的妊娠反應(yīng)。
試管移植后身體發(fā)冷的原因
在進(jìn)行試管移植手術(shù)后,相信很多人都比較關(guān)注的一個問題就是是否著床成功了,畢竟辛辛苦苦這么久,承受了打針和促排等諸多疼痛,就是盼望最后這一刻。而根據(jù)過來人總結(jié)的經(jīng)驗,如果身體突然畏寒怕冷,可能是一種著床或失敗的征兆,但其實并不然,具體引起的原因如下:
1、著床成功
胚胎著床以后,可能會使體內(nèi)的激素分泌發(fā)生變化,從而出現(xiàn)體溫上升的情況,在一定程度上還會出現(xiàn)畏寒的癥狀。這屬于一種正常的現(xiàn)象,一般是不需要進(jìn)行任何治療的,后續(xù)會逐漸消失。
2、感冒了
如果在試管嬰兒移植后,患者突然畏寒,并且覺得一陣陣發(fā)冷的同時,還伴隨有咳嗽、咳痰、鼻塞等不適癥狀,那么要考慮是受涼、急性膽囊炎等其他原因所引起,此時需要進(jìn)行治療。
3、其他健康問題
試管移植后身體發(fā)冷的原因可能有多種,比如上呼吸道感染、急性腸炎等。這些疾病可能由細(xì)菌或病毒感染引起,對此建議患者應(yīng)該要根據(jù)醫(yī)生的建議進(jìn)行相應(yīng)的治療。





